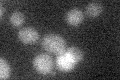
YGL100W
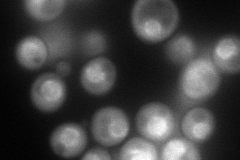
YGL100W
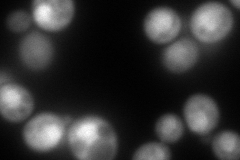
YGL100W
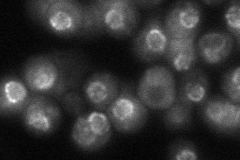
YGL100W
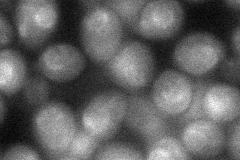
YGL100W
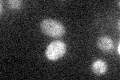
YGL100W

View description
Nuclear pore protein that is part of the evolutionarily conserved Nup84p complex (Nup84p, Nup85p, Nup120p, Nup145p, and Seh1p); homologous to Sec13p
Localization:
Intensity:
Fold change:
Significance:
-
C’ GFP library in SD
below threshold12.61 -
N' NOP1pr-GFP in SD
cytosol,nuclear periphery153.767 -
N' TEF2pr-mCherry in SD
nucleus207.405 -
N' NATIVEpr-GFP in SD
punctate,nuclear periphery50.8647 -
N' TEF2pr-VC and Cyto-VN in SD
nucleus41.7033 -
C’ GFP library in SD+DTT

cytosol14.321.13No -
C’ GFP library in SD+H2O2

cytosol13.971.1No -
C’ GFP library in Starvation Media
cytosol18.91.49No -
C’ GFP library on the background of Pup2-DaMP

below threshold -
C’ GFP library on the background of CCT mutant

below threshold15.77461.25018No
